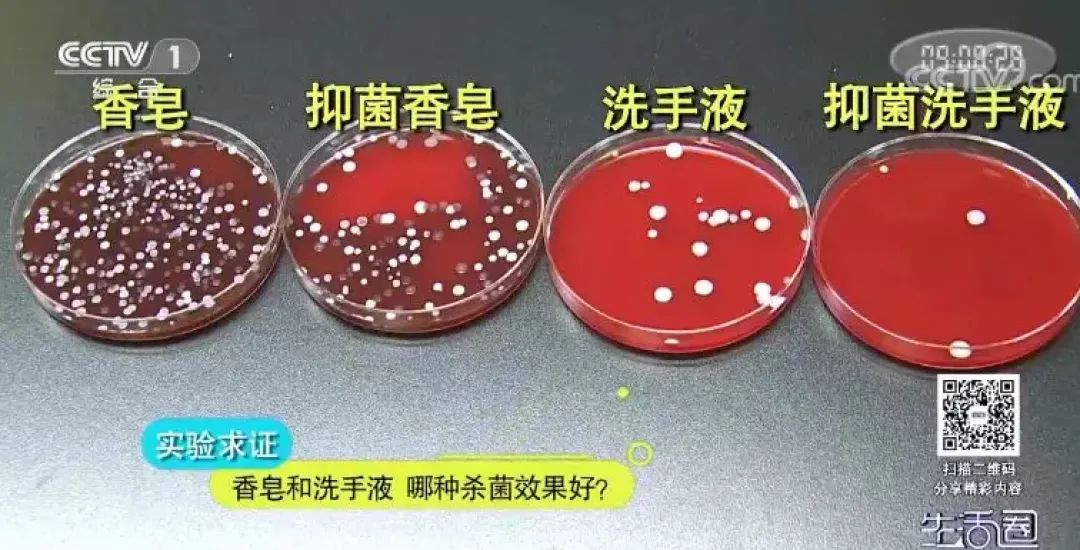

这都可以?(香皂和洗手液的优劣势有哪些)香皂和洗手液的优劣势是什么,震惊!香皂比洗手液更易滋生细菌?,香皂,
勤洗手是保持个人健康的良好习惯
无论是在家里还是在公共场所
洗手液是最常见的
也有很多人会选择用香皂洗手
用哪种洗手更好呢?
一起来看看吧↓
# 一个实验 #
对比的四种洗手用品,分别是普通香皂、带有抑菌功能的香皂,普通洗手液以及带有抑菌功能的洗手液。
先将事先调制好的大肠杆菌培养液等量地涂抹在四位测试者的手掌内侧。涂抹均匀之后,分别对四位测试者手掌上的大肠杆菌进行取样。接下来,请四位测试者分别选择四种洗手用品中的一种,用标准的“六步洗手法”清洗手上的大肠杆菌。
等测试者洗完之后,再次对测试者手上的大肠杆菌进行取样。最后将所有样品放入到恒温箱中,等待48小时。
结果显示,用普通香皂洗手之后手上残留的大肠杆菌数量最多。排在第二位的是带有抑菌功能的香皂。第三位是普通洗手液。大肠杆菌残留最少的是带有抑菌功能的洗手液。
小贴士
无论是香皂或者是洗手液,加杀菌剂的情况下肯定比不加杀菌剂的产品杀菌效果强。
是不是说明在杀菌方面洗手液要比香皂更好呢?

洗手液之所以会比香皂的杀菌效果好,是因为它们所含的表面活性剂种类不同,洗手液中含有的两性表面活性剂在杀菌能力方面更好一些。
不过,两性表面活性剂也有自己的缺点,那就是容易残留在手上。很多人在用洗手液洗手的感受就是,洗完之后虽然看不到泡沫了但感觉手上黏乎乎的,这正是洗手液在手上残留的表现。
建议大家在用洗手液洗手时,应当反复多次冲洗,并通过双手摩擦的方法来判断是否冲洗干净。

香皂长期暴露在空气中,并且处在潮湿环境,很容易滋生细菌而且多人使用容易交叉感染,事实真的是这样吗?

香皂比洗手液更易滋生细菌。
香皂放在一个暴露的空间,在清洗的过程中,手上的细菌留在香皂上。又处在一个潮湿的环境下,细菌就容易在繁殖,长期使用的香皂上都会沾有很多细菌。
洗手液它本身在一个瓶子里,手上的细菌和环境中的细菌进不到瓶子里。从细菌滋生和交叉感染的角度来说,洗手液要明显优于香皂。

小贴士
洗手液在杀菌方面和去污能力上比香皂更强一些,不容易交叉感染,但是清洗不仔细的话容易残留在手上。

香皂的优势在于洗完手之后不易残留,对皮肤的损伤较小。
如果选用香皂的话,最好不要和别人共用,保持皂盒和皂体干燥,以避免交叉感染。
当然,无论是使用香皂还是洗手液,养成良好的、及时洗手的习惯,才是更重要的。

原标题:《震惊!香皂比洗手液更易滋生细菌?》
 售前咨询专员
售前咨询专员